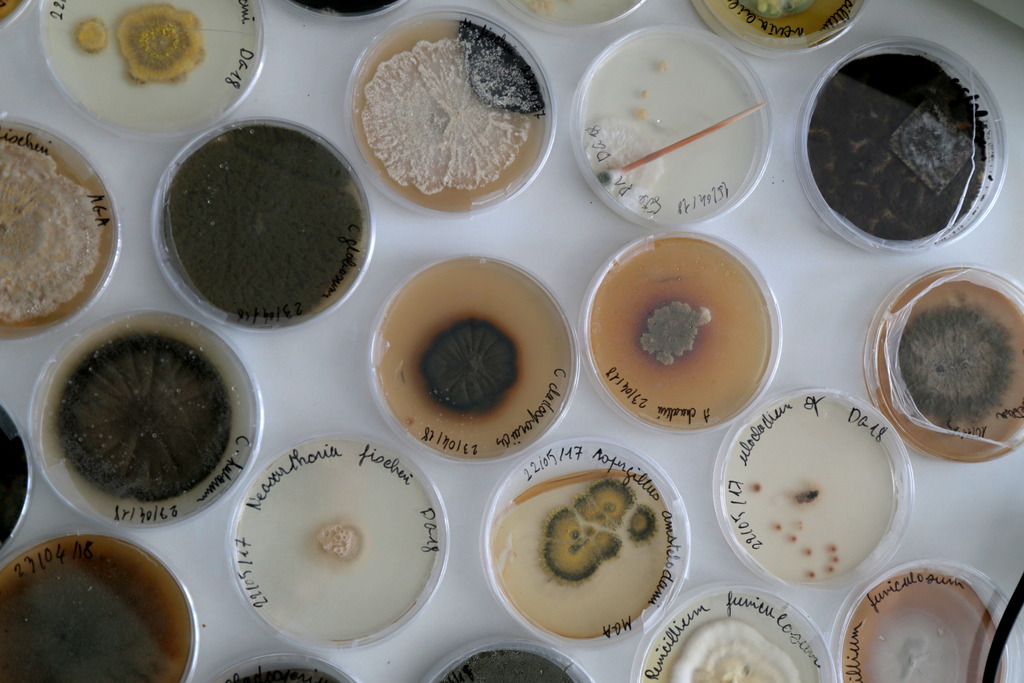

Bien plus qu’un laboratoire d’analyses…
Nous sommes votre partenaire santé au quotidien, alliant expertise médicale, technologie de pointe et accompagnement personnalisé pour des résultats fiables, rapides et à la hauteur de vos attentes.
Laboratoire d'analyses médicales
Nous réalisons des analyses précises et conformes aux normes internationales.
Analyses précises par des scientifiques experts
Nos équipes assurent des tests fiables, avec rigueur et une expertise scientifique reconnue.

Présentation de Docteure
Dr Alouhmy Fatima Zahra
Dr Alouhmy accorde une attention particulière à la qualité, à la précision scientifique et à l’accompagnement humain des patients tout au long de leur parcours d’analyse. Sa vision : un laboratoire où l’excellence scientifique rencontre la bienveillance humaine.
Techniciens de laboratoire
Nos techniciens assurent des analyses précises et un suivi rigoureux des échantillons.
Centre de recherche
Un centre dédié à l'innovation et à l'excellence scientifique pour des résultats fiables.
- Diplômée de la Faculté de Médecine et de Pharmacie de Casablanca
- Diplômée en Management de la Qualité – Université de Bordeaux
- Diplômée en Médecine et Biologie de la Reproduction – Sorbonne Université, Paris
- Ancien médecin interne au CHU Ibn Rochd de Casablanca

À propos du Laboratoire Central de Ain Sbaa
Le Laboratoire Central de Ain Sbaa met à votre disposition une équipe qualifiée et des équipements de dernière génération, garantissant des analyses biologiques fiables, rapides et sécurisées.
Notre mission est d’offrir un service d’excellence, fondé sur la rigueur scientifique, la confidentialité, et un accompagnement personnalisé pour chaque patient.
- Analyses réalisées selon les normes internationales
- Résultats disponibles en ligne ou sur place
- Service de conseil biologique et suivi personnalisé
- Respect strict des procédures de qualité
- Système LIS garantissant la traçabilité et la sécurité des données
- Délais rapides grâce à une organisation efficace
Domaines d’expertise
Chaque analyse est effectuée avec des équipements modernes et soumise à un contrôle qualité rigoureux, pour garantir des résultats fiables à 100 %.

Hématologie

Hémostase

Immunologie

Biochimie Clinique

Biologie de la Reproduction

Parasitologie
Mycologie

Bactériologie

Virologie

Biologie Moléculaire
Nos partenaires
CMIM, MUPRAS, LICCILINE, et plusieurs autres institutions de santé font confiance à notre savoir-faire.
Recent Posts
Vous avez des questions ?
Un espace d’information et de sensibilisation pour mieux comprendre votre santé.
Categories
Espace Blog Santé
Découvrez notre espace blog, dédié à la prévention et à la santé au quotidien Chaque mois, nos biologistes partagent des articles simples et clairs sur divers sujets
Espace Blog Santé
Prévention des maladies saisonnières
Lorem ipsum dolor sit amet, consectetur adipiscing elit. Donec vel dignissim lectus. Pellentesque
L’importance des bilans de santé réguliers
Lorem ipsum dolor sit amet, consectetur adipiscing elit. Donec vel dignissim lectus. Pellentesque
Comprendre ses résultats d’analyse
Lorem ipsum dolor sit amet, consectetur adipiscing elit. Donec vel dignissim lectus. Pellentesque
Conseils pour renforcer son immunité
Lorem ipsum dolor sit amet, consectetur adipiscing elit. Donec vel dignissim lectus. Pellentesque
Contact & Accès
Entrer en contact
Adresse
RDC N°8, Bd Ahmed Mekouar, Aïn Sbaa – Casablanca
Téléphone
Horaires d’ouverture
Lun - ven : 7h30 à 18h30
Samedi : 7h30 à 13h00







